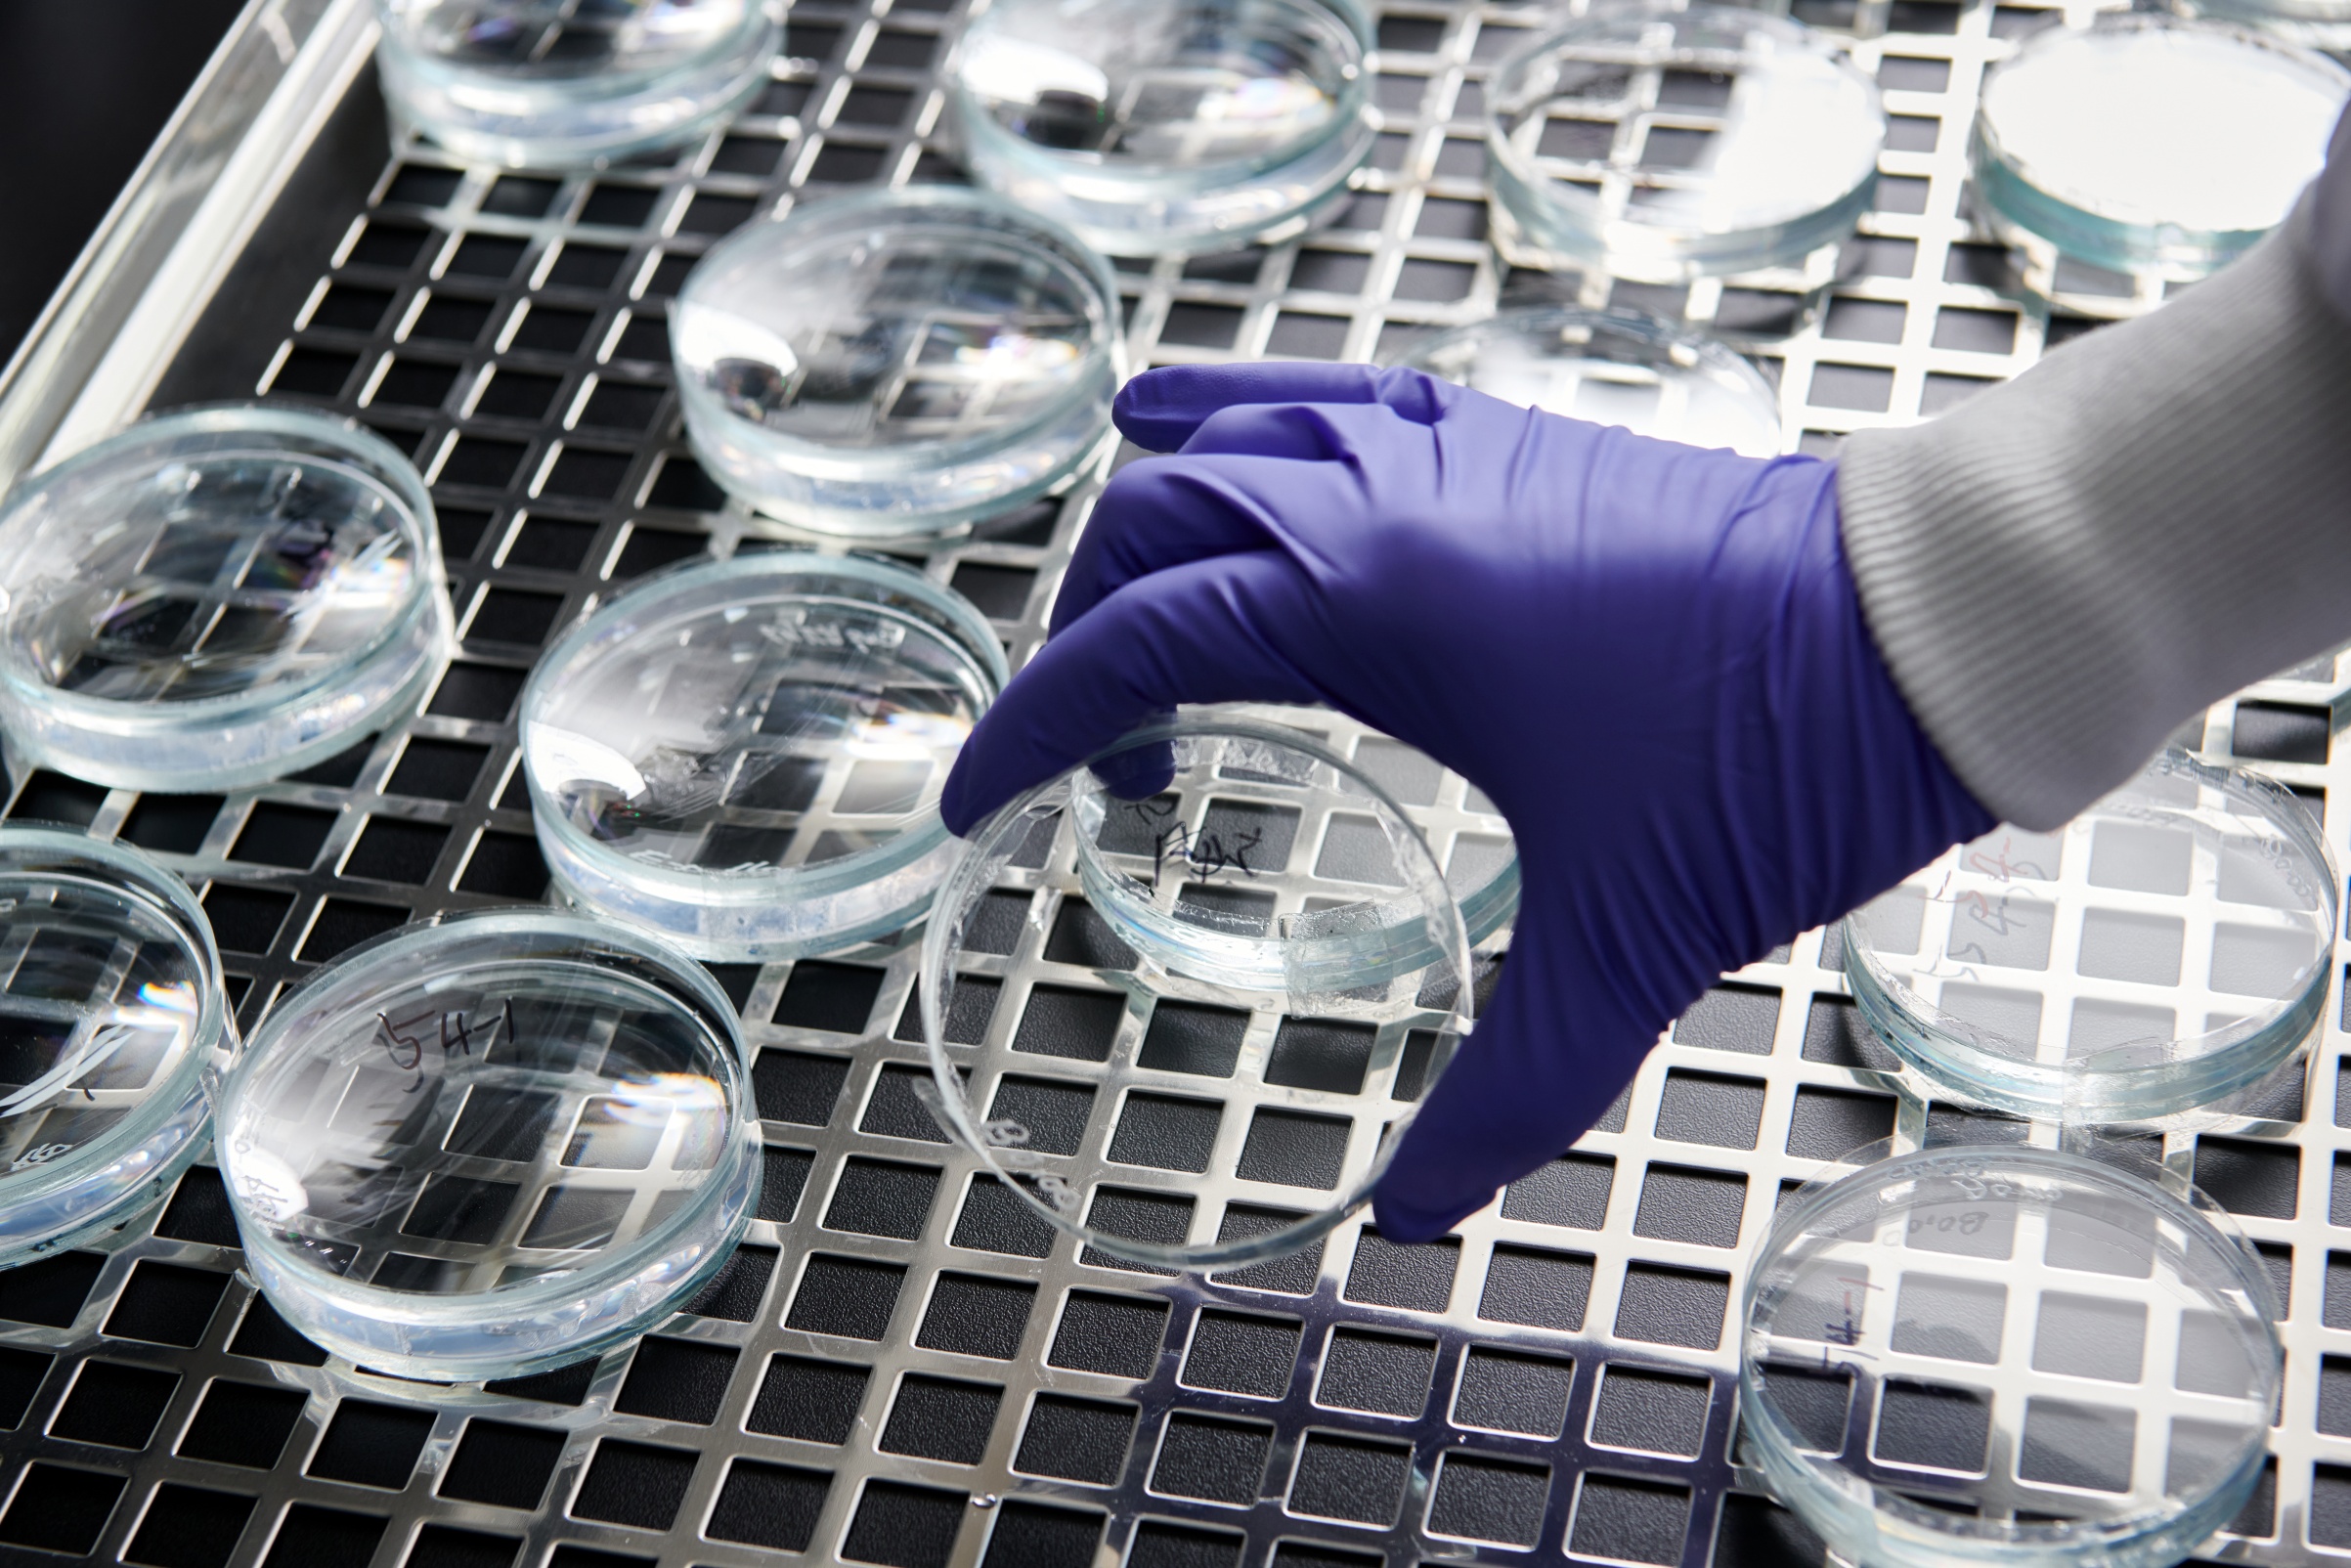

안녕하세요. TDI생산팀 서보원 프로입니다.
TDI는 Polyol, MDI 등과 함께 폴리우레탄 제조의 기초원료 사용되는 TDI는 연질폼, 도료, 접착제 등의 용도로 사용됩니다.
한화솔루션 케미칼 부문은 TDI를 시작으로 폴리우레탄 산업에서의 글로벌 경쟁력을 확보하기 위해 사업영역 확장 및 고부가가치 제품 개발을 지속하고 있습니다.

한화솔루션 TDI 생산팀 엔지니어의 하루는요,
매일같이 바쁘게 돌아가는 일상 속에서 한화솔루션 엔지니어는 어떻게 시간을 보내는지 궁금하시죠?
그럼, 저와 함께 하루를 시작해볼까요?

아침 8시, 하루를 시작하면서 제일 먼저 하는 일은 공정 이슈를 파악하고 전날의 Daily 정산을 확인하는 것입니다. 어제 발생한 문제점이나 개선사항을 체크하면서 오늘의 업무 계획을 세웁니다. 이 시간이야말로 하루 업무의 기초를 다지는 중요한 순간이죠.
회의가 끝나면, 원부원료 재고를 파악하고 제품 출하 일정을 관리하는 업무에 돌입합니다. 정확한 재고 파악과 일정 관리는 원활한 생산과 출하를 위해 필수적이므로, 이 과정은 매우 신중하게 진행합니다. 재고가 부족하지 않도록 꼼꼼히 체크하는 것이 포인트입니다.
점심 식사 후에는 현장 확인과 제품 입고 및 출하 관리 업무를 진행합니다. 직접 현장을 둘러보며 이상이 없는지 확인하고, 입고된 제품들이 제대로 관리되고 있는지 체크합니다. 또한, 출하가 원활하게 이루어질 수 있도록 모든 과정을 꼼꼼히 살펴봅니다.
오후근무시에는 기타 서류 업무와 공정 모니터링 시간을 가집니다. 각종 서류를 정리하고, 공정이 원활하게 진행되고 있는지 모니터링합니다. 이 시간에는 주로 컴퓨터 앞에 앉아 업무를 처리하는 경우가 많습니다.
마지막으로, 내일의 업무를 리스트업하며 하루를 마무리합니다. 내일 해야 할 일을 미리 정리해두면, 보다 효율적으로 업무를 시작할 수 있답니다. 모든 준비를 마친 후 퇴근을 하면서 하루 일과를 돌아보며 보람을 느낍니다.

TDI 및 XDI 공정의 개선점들을 파악하고 해결하여, 공정의 효율을 높이는 데 기여하고 싶습니다. |
엔지니어 서보원 프로의 한화솔루션에서의 활약을 기대해주세요.
* 이 콘텐츠의 모든 저작권은 한화솔루션(주)에 있습니다.